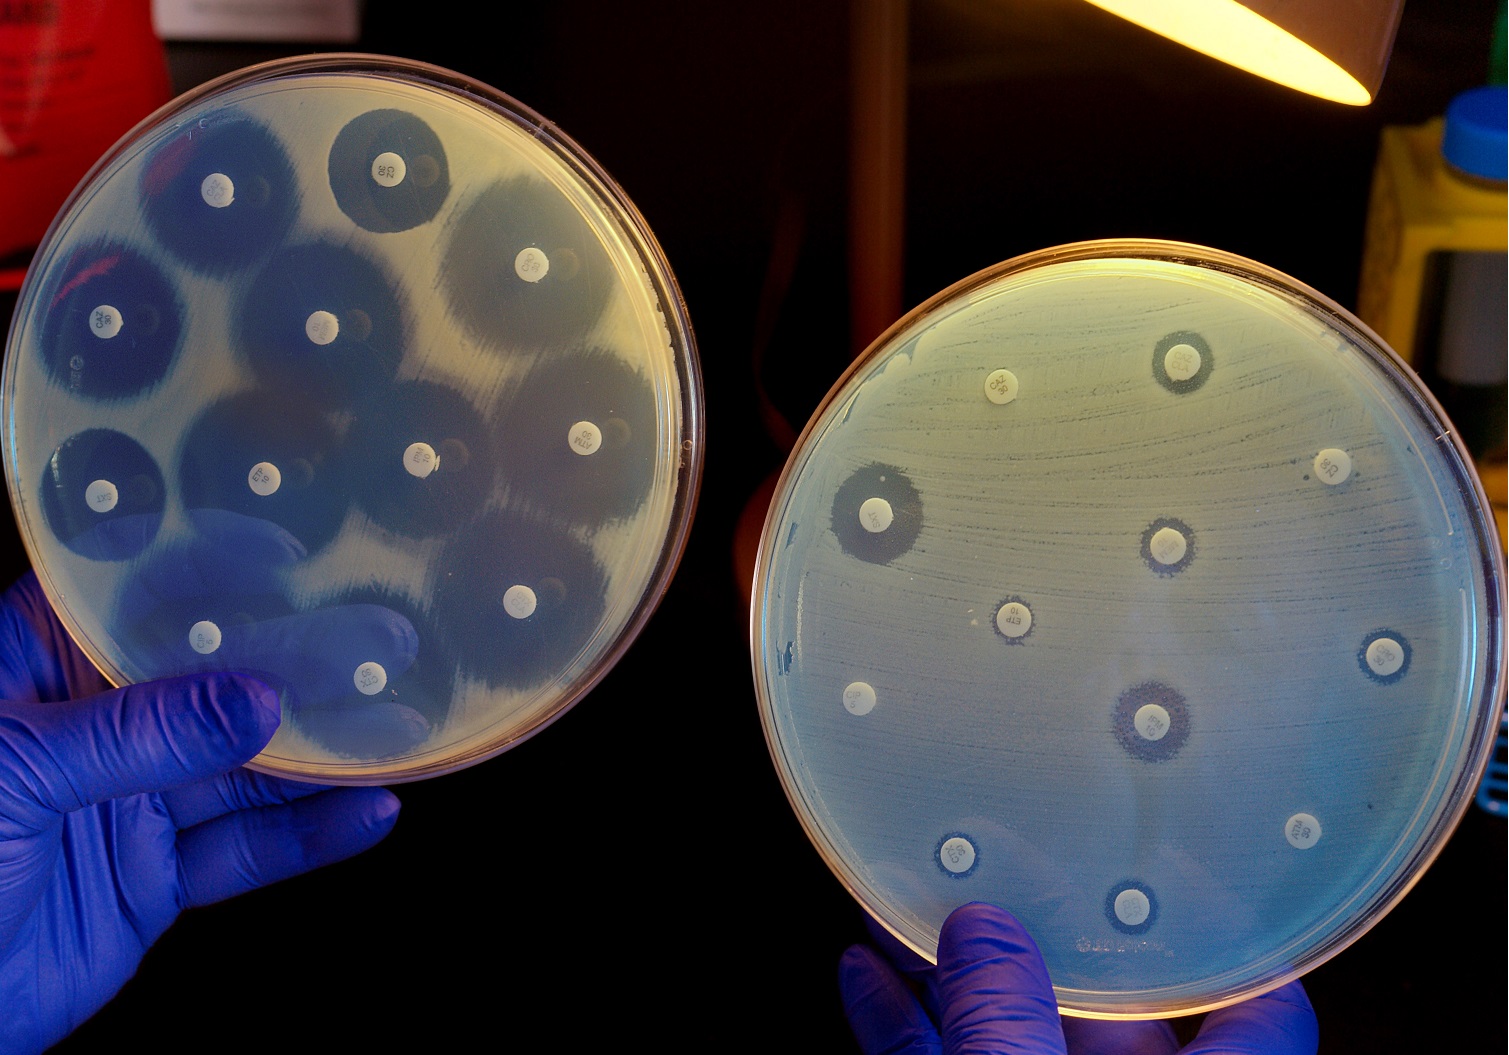

Principles of Antibiotic Therapy
Prof. Russell Lewis
Department of Molecular Medicine
University of Padua
russelledward.lewis@unipd.it
https://github.com/Russlewisbo
slides available at: www.padovaid.com
 |
Antibiotics- The Medical Miracle
Medicine in the pre-antibiotic era
Dawn of antibiotic discovery
| Paul Ehrlich Salvarsan 1909 |
Alexander Fleming Purified and tested by Florey, Chain, Heatley-1940 |
Gerhard Domagk, Sulfanilamides 1931 |
|---|---|---|
 |
 |
 |
Mortality reduction with antibiotic therapy
| Disease | Pre-antibiotic era | Antibiotic era | Change |
|---|---|---|---|
| Community-acquired pneumonia | ~ 35% | ~ 10% | -25% |
| Nosocomial pneumonia | ~ 60% | ~ 30% | -30% |
| Bacterial endocarditis | ~ 100% | ~ 25% | -75% |
| Gram-negative bacteremia | ~ 70% | ~ 10% | -60% |
| Bacterial meningitis | > 80% | < 20% | -60% |
| Cellulitis | ~ 11% | < 0.5% | -10% |
Antibiotics:
Essential for practice of modern medicine
Enable complicated and deeply-invasive surgery
Aggressive chemotherapy for cancer
Fundamental aspects of critical care
- e.g., central venous catheters, mechanical ventilation
Care for premature infants, mothers (post-partum sepsis)
Solid organ and stem cell transplantation
Antibiotics created a revolution in the practice of medicine, transforming a primarily diagnostic-focused field to a therapeutic, interventional profession
Current antibiotic resistance statistics
World Health Organization (WHO)
Pathogen Priority List
Methicillin-resistant
Staphylococcus aureus (MRSA)
Carbapenem-resistant Enterobacterales (CRE)
Multi-drug resistant (MDR)
Acinetobacter baumannii
Antibiotic discovery is slowing
Antibiotics are a societal trust
Antibiotic overprescription is a tragedy of the commons: individual undertakes an action that they perceive to be in their own self-interest but that causes harm to society at large
When such an action is undertaken rarely, the harm to society is not noticeable
When it happens tens of millions of times per year, as with inappropriate antibiotic prescriptions, the collective harm to society can be catastrophic
Given the power of antibiotics to save lives, and the constant erosion of that power through their use, one of the most important functions of the physician is to serve as an expert in the use and protection of antimicrobial agents
Antibiotic stewardship
 |
 |
Principles for effective antibiotic use
Accurate differential diagnosis
Only use antibiotics when they alter the clinical course of disease
Empirically target microbes in differential diagnosis
A lower threshold for empirical therapy should be used in critically-ill patients
Host factors affect the spectrum of empirical therapy
Use PK/PD principles to select and optimally dose treatment
De-escalate antibiotic therapy based on microbiology results and clinical (biomarker) responses
If therapy is not working, consider source control or alternative diagnosis before broadening therapy
Distiniguish new infection from failure of initial therapy
The duration of therapy should be as short as possible based on available evidence (shorter is better)
Principle #1: Develop an accurate
differential diagnosis
What is the most important component in diagnosing infectious diseases?
A. Patient medical history
B. Physical exam
C. Radiological imaging (e.g., X-ray, CT or MRI)
D. Biomarkers of infections (e.g., c-reactive protein, procalcitonin)
E. Microbiological tests (e.g., culture, PCR, serology)
Medical history is 80% of diagnosis?
What are the current symptoms (e.g., fever, pain, cough, breathlessness, confusion, lethargy, vomiting, and any acute or subacute changes in functional status such as new urinary incontinence, falls, or decreased oral intake)
- 8 cardinal descriptors: Timing, Location, Character, Aggravating factors, Alleviating factors, Associated symptoms, Severity, Setting
Fever How high, how long, what pattern?
Risk factors for infection (e.g., indwelling devices -urinary catheters, vascular catheters, prosthetic joints, cardiac devices), recent medical procedures, immunosuppression, diabetes, history of injection drug use, and previous infections
Travel or exposure history (e.g., recent travel -countries, regions, urban/rural, dates, exposure to animals or insect bites, contact with ill individuals, and consumption of potentially contaminated food or water)
Sexual history and risk for sexually transmitted infections
Vaccination history
Past medical and surgical history, medication use, and allergies?
Recent changes in medications or antibiotic use?
Social history? (e.g. long-term care facility, occupation, hobbies, substance use, unusual exposures)
Case Example
Chief complaint: 34 year-old farmer from Sicily presents with worsening back pain after sitting for more than couple of hours
No other significant past medical history
Spondylitis etiologies:
> 50% Staphylococcus aureus, Staphylococcus epidermidis
~ 25% Streptococcus spp., Enterococcus spp. Pseudomonas aeruginosa, Enterobacter spp., Proteus spp. E. coli, Serratia spp., Anaerobes, Mycobacterium tuberculosis (Pott’s disease)
Pertinent history
Patient works as a sheep and cattle farmer in a small enterprise 54 minutes from Messina that produces milk and cheese: Percorino salato and Ricotta
Patient reported pain was first noticed at end of May after a bad case of flu “fever, achy joints, headache”
Father (who also works on farm) also has worsening hip pain after sitting for long periods and will be evaluated by an orthopedic doctor for hip replacement
Other 3 brothers and cousin who work on farm report no illness
Could this be brucellosis?
 Zoonotic Gram-negative coccobacilli
Zoonotic Gram-negative coccobacilli
Diagnosis and treatment of
Brucellosis spondylitis:
Blood cultures require special procedures (prolonged incubation), bone biopsy culture may be needed
Brucella PCR from clinical specimen
Combination serologic studies
Treatment- Gentamicin + Doxycycline + Rifampin
- Unconventional treatment: would not be covered by standard spondylitis treatment regimens
Antibiotics are usually started empirically
Antibiotics are usually started empirically
Antibiotics should only be started if the differential diagnosis includes likely invasive bacterial infections:
>90% of upper respiratory tract infections are caused by viruses
Doctors frequently underestimate the risks of antibiotic therapy
1 in 5 patients given antibiotic prescriptions are harmed by them because of adverse events or superinfection by resistant pathogens or Clostridioides difficile
Every additional 10 days of antibiotic therapy confers a 3% increased risk of an adverse drug effect
A combination of:
Fear from uncertainty of the diagnosis
Lack of appreciation of how dangerous antibiotics can be
Association of adverse events with antibiotic use in hospitalized patients
Positive cultures
are not always proof of infection
A positive culture in the absence of signs or symptoms of infection should not reflexively trigger antibiotic therapy
Without symptoms, a positive culture often represents colonization or contamination
| Wound swabs | Urine cultures | Bronchial alveolar lavage | Respiratory samples | GI tract/stool |
|---|---|---|---|---|
 |
 |
 |
 |
 |
Simple stewardship interventions
Simple stewardship intervention
Principle #2: Only use antibiotics when they alter a patient’s clinical course of patients
Antibiotics are not the only answer
The administration of antibiotics should not be a reflexive response to infection, but should be incorporated into an overall, rational therapeutic plan for the patient.
Patients who lack bacterial infections cannot have their clinical course improved by antibiotics (as discussed in Principle #1).
Ethical dilemmas for use of
antimicrobial therapy
| End of life (comfort care) | Non-adherent HIV therapy |
|---|---|
 |
 |
Principle #3: Empirically target microbes in differential diagnosis
Know the spectrum of activity
|
Community-acquired vs. nosocomial
Basic principles of coverage
| Community infections | Nosocomial infections |
|---|---|
|
|
| Avoid using routine methicillin-resistant S. aureus (MRSA) empirical therapy in patients who are unlikely to be infected with MRSA | Greater risk for MRSA, especially is patient has recently received antibiotic therapy |
| Reserve the use of antimicrobials that can be used as last-line oral therapeutic options (e.g., fluoroquinolones) for infections for which there are no reasonable alternative therapies | May require “frontline” used of lastline antibiotic if patient has risk factors for multidrug resistant infection |
Special circumstances create exceptions: For example, community-acquired pneumonia and intraabdominal, skin, and urinary infections may be caused by Pseudomonas in patients with cystic fibrosis or with history of bronchiectasis, chronic dialysis patient, or patient with indwelling catheters or recent surgery.
Principle #4: There is a lower threshold for empirical therapy in critically-ill patients
Antibiotic timing is critical in septic shock
Principle #5: Host factors affect the spectrum of empirical therapy
Common immunocompromised conditions
 |
|
Glucocorticoids:
“Credit cards” of immunosuppressive therapy
Dose-dependent increase in the risk of opportunistic infections > 10 mg of prednisone equivalents (PEQ) per day for 2-4 weeks
Community acquired pneumonia (CAP)
vs. Pneumocystis jirovecii pneumonia (PCP)
|
Diffuse bilateral infiltrates |
Patchy areas of ground-glass attenuation |
Principle #6: Use PK/PD principles to optimize
treatment selection and dosing
Pharmacology of antimicrobials
Key pharmacokinetic variables
Key pharmacokinetic variable:
Volume of distribution (Vd)
The volume which appears to hold the drug if it was present in the body at the same concentration found in plasma
- It is estimated, not directly measured
Reported in liters (L) or liters per kilogram (L/kg)
Average plasma volume in adults is approximately 3 L
Key pharmacokinetic variable:
Volume of distribution (Vd)
Volume of distribution
Volume of distribution (Vd):
relevance for antibiotic selection
Vd alterations
Vd changes in critical illness
Drug penetration in ventilator-associated pneumonia
Anatomically-privileged sites
Anatomically-privileged sites
Match the antibiotic to site of infection
Urinary concentrations of antibiotics
Second key pharmacokinetic variable:
Clearance (CL)
Drug elimination from the body
Described by volume of blood removed of drug unit per time
Unit of measure mL/min or L/hr
Clearance is affected by patient’s disease, organ function genetics, interactions with other drugs…etc.
Total body clearance:
- CL renal + CL hepatic + CL other
Formulas for calculating antibiotic clearance can be found in the medical literature or some drug references
Important distinctions between
Vd and CL in antibiotic dosing
Vd and CL are both physiologically-based
A change in patient fluid status or distribution can affect volume of distribution (Vd)
A change in patient kidney or liver function affects drug clearance (CL)
However, these parameters do not directly interact with each other
- A change in volume of distribution does not change clearance and vice versa
Volume of distribution is useful for calculating an initial dose of antibiotic regimens (loading dose)
Clearance is useful for calculating maintenance doses of antibiotic regimens
- CL is NOT USED to determine how much of an initial dose (or loading dose) of an antibiotic to give to a patient
Most antibiotics are eliminated via the kidneys and maintenance doses must be adjusted for renal function
Estimating renal function
Cockcroft-Gault formula (other formulas MDRD…etc.)
\[ \text{CrCl (mL/min)} = \frac{(140 - \text{age}) \times \text{weight (kg)}}{72 \times \text{SCr (mg/dL)}} \times 0.85 \text{ (if female)} \]
Formula developed primarily in Caucasian males with chronic renal disease
Does not take into account effects on older age, comorbidities and drug interactions with renal tubular secretion
Antibiotic dosing in dialysis (drug-specific dosing guidance)
Problems of using serum creatinine-based dosing adjustments
Antibiotic renal dose adjustments in drug labels are based on patients with chronic kidney disease
Renal impairment is acute, not chronic, in up to 50% of patients with infection and frequently resolves within the first 48 hours
Creatinine-based equations for estimates of CrCl are based on steady-state conditions, and not as accurate in acute kidney injury
- Decreases in SeCr are delayed with respect to injury resolution
Renal dose reduction in the first 48 hours of therapy may unnecessarily result in underdosing of antibiotics, especially for safe antibiotics
Hepatic clearance of antibiotics
Drug interaction screening
UptoDate
PK/PD indices
How is the PK/PD index identified?
How are PK/PD indices identified?
Do PK/PD indices correlate with
clinical outcome of antibiotic therapy
PK/PD characteristics of common
antibiotic classes
Application: Optimized dosing of meropenem
Daptomycin is inactivated in the lung
Antibiotic activity in abscess
Aminoglycosides
Bind and are inactivated by purulent material
Decrease aminoglycoside uptake into facultative aerobic bacteria at low pH
Penicillins and tetracyclines
Bound by hemoglobin, less effective with hematoma formation
Emphasizes importance of source control (abscess drainage, removal of prosthetic material)
Principle #7: De-escalate antibiotic therapy based on microbiology results and clinical (biomarker) responses
Antibiotic de-escalation
De-escalation with pathogen identification
- e.g., stopping empirical vancomycin in patient with Gram-negative bacilli in blood cultures
Clinical improvement-reduction in fever and leukocytosis
Empiric de-escalation of therapies for highly-resistant pathogens if they have not grown from culture
- e.g., stopping empirical vancomycin in a patient without positive MRSA cultures
Biomarkers: C-reactive protein (clinical utility questioned), procalcitonin -areas of diagnostic stewardship as tests are frequently abused
Incorporation of procalcitonin into therapeutic decisions reduces antibiotic use
Choosing therapy :
gram-stain vs. guidelines
Gram strain guided therapy resulted in a 30% reduction in use of anti-pseudomonal agents and 40% reduction in MRSA agents
Gram-stain guided therapy resulted in higher rate of appropriate antibiotic escalation (7% vs. 1%, p=0.03)
Susceptibility testing-Mean inhibitory concentration
Principle #8: If therapy is not working, consider source control or alternative diagnosis before assuming resistance and broadening therapy
Consider changing antibiotics of the following parameters do not improve:
- Fever curve
- White blood cell count
- Purulent secretions
- Signs of inflammation (rubor, tumor, dolor, calor)
- Biomarkers (procalcitonin)
Source control
| Occult subcutaneous abscess in cellulitis | New abscess formation in intraabdominal infection | Empyema in community-acquired pneumonia | Visceral or skeletal abscess in patient with bacteremia | Failure to remove a central venous catheter |
 |
 |
 |
 |
 |
Biofilms: A key source of antibiotic failure
Antibiotic FAIL
False diagnosis
Allergies
Intercurrent infections
Localized process
Principle #9: Distinguish new infection from failure of initial therapy
New onset of infectious signs, symptoms, and biomarkers after resolution of prior infection should raise the concern of a new infection rather than persistence of the original infection
Rarely, recrudescence of signs and symptoms may reflect emergence of antibiotic resistance on therapy from the initial pathogens
This may be seen more with specific bacterial pathogens, such as Acinetobacter baumannii, than with others
An initial apparent response to infection followed days or weeks later by new onset of infectious signs or symptoms should prompt a complete reevaluation of the patient for a new infection, including reculturing and imaging if necessary
In these patients, it is generally reasonable to broaden therapy to cover highly resistant pathogens
- Such patients have been exposed to recent courses of antibiotics and have a higher risk of being infected by antibiotic-resistant pathogens
When changing antibacterial therapies because of breakthrough infection or lack of response to initial therapy, it is generally advisable to change one antibiotic at a time (to a different class if possible)
Principle #10: The duration of therapy should be as short as possible based on evidence
| Disease | Short course (days) | Long course (days) | Outcome |
|---|---|---|---|
| Bacteremia, gram-negative | 7 | 14 | Equivalent |
| Chronic bronchitis and COPD | ≤ 5 days | ≥ 7 | Equivalent |
| Intra-abdominal infection | 4 | 10 | Equivalent |
| Neutropenic fever | Until afebrile and stable | Until, afebrile, stable and non-neutropenic | Equivalent |
| Osteomyelitis, chronic | 42 | 84 | Equivalent |
| Pneumonia, community-acquired | 3-5 | 7-10 | Equivalent |
| Pneumonia, nosocomial (including VAP) | ≤ 8 | 10-15 | Equivalent |
| Pyelonephritis | 5-7 | 10-14 | Equivalent |
| Skin infections (cellulitis, major abscess, wound infections) | 5-6 | 10-14 | Equivalent |
| Sinusitis, acute bacterial | 5 | 10 | Equivalent |
Common myths of antibiotic therapy
Myth 1:
“Bactericidal” antibiotics are more effective
than “bacteriostatic”
Bactericidal activity: concentration of drug that results in 1000-fold reduction in inoculum within 24 hours
Bactericidal antibiotic: MBC of drug is 4-fold or less above the MIC
However, “bacteriostatic” drugs do kill bacteria, they just require higher concentrations
Systematic literature reviews: cidal vs. static
antibiotics for bacterial infections*
56 randomized controlled trials identified
49/56 found no difference in clinical outcomes, including highly-lethal infections in critically-ill patients
- Typhoid fever, severe pneumonia, severe sepsis
6 trials reported linezolid (static antibiotic) to be superior to “cidal” agents (vancomycin, teicoplanin or cephalosporins)
1 trial found imipenem superior to tigecycline in ventilator associated pneumonia- however tigecycline dosage was too low:
- A subsequent study using double to dose of tigecycline found no difference
Other examples where more rapid bactericidal activity failed to show clinical superiority
Daptomycin (rapidly bactericidal) vs. vancomycin (slowly bactericidal) against Staphylococcus aureus bacteremia and right-sided endocarditis
Addition of aminoglycosides to ß-lactams or ß-lactams to vancomycin/daptomycin results in more rapid kill of staphylococci, but in clinical trials no improvement in outcomes and higher rates of nephrotoxicity
Bacterial endocarditis: Historical artifact?
Early studies compared high Vd drugs (tetracyclines, marcolides) to penicillins (low Vd drugs) for endocarditis
Low blood concentrations with tetracyclines and macrolides makes them a poor choice for high-grade bloodstream infections
Myth 2: Oral antibioic therapy is less effective
than IV for complex infections
Osteomyelitis: Earlier studies with oral sulfanilamide, erythromycin, tetracycline with low blood and bone concentrations were associated with higher failure rates-did not surpass pathon MICs
However, numerous modern antibiotics can acheive levels in blood and bone that are well in excess of target pathogen MICs
Oral is the new IV
Transitioning to oral therapy:
Key considerations
Is the patient hemodynamically stable?
Will the patient absorb the medication (functioning GI tract)?
Can the patient take drugs by mouth
Do we have an antibiotic option with good bioavailability for the infection?
Oral bioavailability of antibiotics
Myth #3: Combination therapy:
The good, the bad,…and the ugly
Are 2, 3 or 4 drugs better than 1?…..it depends on the situation
Synergistic combination the killing effect of two or more antibiotics is greater than the added effect of each antibiotic by itself
Clinically, suggests that the success rate (however measured) is better when the two antibiotics are administered simultaneously
Microbiological rationale: Checkerboard test
Combination therapy: The good
Spectrum: More than one drug is required to provide adequate coverage
e.g., adding macrolide or doxycycline to cover atypical pathogens not treated by backbone ß-lactam
Specific ICU ward or hospital ward with high rates of MDR- Two drugs may have greater coverage of MDR pathogens
Preventing emergence of resistance in specific clinical scenarios
Tuberculosis: Slow growth, non-replicating or low-replicating persister cells and can achieve high bacterial densities in cavitary disease with spontaneous mutations
HIV and hepatitis C: Resistance converts a treatable (HIV) or curable (HCV) infection into a fatal illness
Combination therapy: The good, cont.
Two active agents results in superior clinical outcomes compared to single active agent
Slow growing infection/non replicating persisters- e.g. anti-tubular activity of rifampin and PZA ensure (1) empirical therapy is active; (2) prevent emergence of resistance; (3) improve clinical cure with shorter duration of therapy
Bone and joint infections (nonreplicating bacteria in biofilm): Reduced relapse rates with addition of rifampin, especially to fluoroquinolones
Exotoxin-mediated infections-
Necrotizing fasciitis
- Streptococci or Clostridium infections that are extremely destructive and aggressive
- Addition of clindamycin or linezolid as a 2nd agent terminates protein synthesis: shutting down toxin production in the bacteria
- Adding protein synthesis inhibitors to backbone antibacterial therapy has been associated with improved survival in retrospective studies
Eukaryotic infections:
Combination therapy is beneficial
Cryptococcal meningitis (fungal infection): Amphotericin B + 5-FC
Protozoal infection (Plasmodium vivax P. ovale): Primaquine added to backbone therapy to kill hepatic -phase hypnozoites not killed by other agents, which lead to late relapse
Acute amebic colitis: Metronidazole + luminicidal agent (iodoquinol or paromomycin) to kill encysted, non-meatabolically active organisms in the bowel lumen
Nematode infections: Doxycycline added to ivermectin or albendazole to kill commensal bacteria Wolbachia, which play a role in the parasite viability and fertility.
Neurocystosis: Albendazole plus praziquantel: Dual mechanism of killing and pharmacokinetic interaction leading to higher drug exposures in the CNS and cysts within the sequestered site
Combination therapy the bad-Redundant definitive therapy for “typical infections”
Very few data supporting the use of two active agents for acute, pyogenic bacterial infections
Organisms are in planktonic growth, not multiple phases of life cycle
No commensal organisms inside the bacteria to kill
Pharmacology and killing activity of single agents is good
Combination therapy for
Pseudomonas aeruginosa
Combination therapy studies for severe infections/sepsis have also found no advantage for dual therapy
Dual therapy more likely to result in toxicity and microbiome harm- potential resistance to 2 drug classes
Combination therapy- The ugly: imperfect data
Fungal infections outside cryptococcosis
Candida infections- no clear benefit
Aspergillus infection- possible benefit with echinocandins and triazoles
Does combination therapy prevent resistance?
Yes- Tuberculosis, HIV, HCV
In test tubes (in theory) against pyogenic bacteria it may work- but Pyrrhic victory- greater selection for resistance, greater impact on microbiome?
Conclusions
- Antibiotic therapy are miracle cures that have fundamentally altered the practice of medicine
- Their incredible power to effectively treat patients is fleeting
- Physicians bear the burden of using antibiotics effectively to heal and cure patients while preserving this awesome power
References